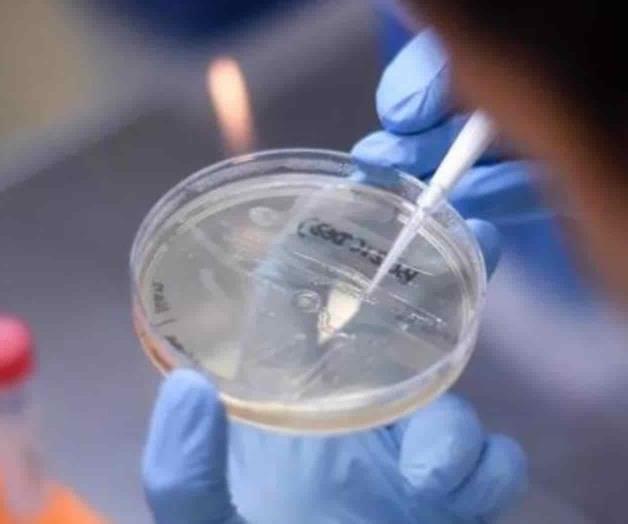
Causa variante Delta nuevos confinamientos Causa variante Delta nuevos confinamientos

Causa variante 'Delta' nuevos confinamientos
Estimaciones sugieren que puede ser entre 60 y 50 por ciento más contagiosa que la versión Alpha, de origen británico
Estimaciones sugieren que puede ser entre 60 y 50 por ciento más contagiosa que la versión Alpha, de origen británico.
Ciudad de México.- La propagación de la variante "Delta" del SARS-CoV-2, que, según la OMS, es la más contagiosa de todas las cepas, está forzando a reimponer nuevas restricciones ante el alza de nuevos casos que ha provocado en algunos países, lo que deja un recordatorio de que la pandemia está lejos de terminar.
En Australia, los brotes de la variante de origen indio forzaron a cuatro grandes ciudades -Sidney, Brisbane, Perth y Darwin- a confinamientos estrictos desde el fin de semana. En Malasia, el Gobierno dijo el lunes que las órdenes nacionales de quedarse en casa serían extendidas indefinidamente.
Irlanda, por su parte, retrasará la flexibilización de algunas restricciones de bloqueo; Alemania está considerando introducir controles adicionales en las fronteras, y en Bangladesh soldados se preparaban para patrullar las calles y cuidar el cumplimiento del confinamiento.
Delta supone en torno al 90 por ciento de los nuevos casos en Rusia, 80 por ciento en Reino Unido, 50 por ciento en Alemania, y 20 por ciento en Estados Unidos e Israel.
La Organización Mundial de la Salud identificó a la variante india como "de preocupación". Estimaciones sugieren que puede ser entre 60 y 50 por ciento más contagiosa que la versión Alpha, de origen británico.

